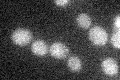
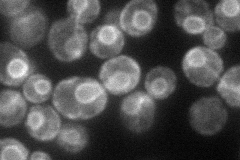
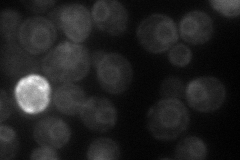
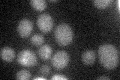

View description
Sphingolipid alpha-hydroxylase, functions in the alpha-hydroxylation of sphingolipid-associated very long chain fatty acids, has both cytochrome b5-like and hydroxylase/desaturase domains, not essential for growth
Localization:
Intensity:
Fold change:
Significance:
-
C’ GFP library in SD
below threshold15.32 -
N' NOP1pr-GFP in SD
ER65.315 -
N' TEF2pr-mCherry in SD
ER46.2568 -
N' NATIVEpr-GFP in SD

ER34.3883 -
N' TEF2pr-VC and Cyto-VN in SD

ER39.9419 -
C’ GFP library in SD+DTT

cytosol171.1No -
C’ GFP library in SD+H2O2

cytosol17.071.11No -
C’ GFP library in Starvation Media
cytosol25.171.64No -
C’ GFP library on the background of Pup2-DaMP

below threshold -
C’ GFP library on the background of CCT mutant

below threshold16.21881.05815No
